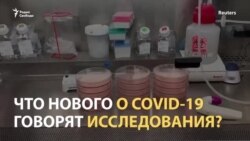
Что нового в мире в исследованиях COVID-19?

Президент Владимир Путин объявил 11 августа о регистрации в России первой вакцины от COVID-19. Таким образом, она стала первой зарегистрированной вакциной от коронавирусной инфекции в мире.
Путин заявил об этом, открывая во вторник совещание с членами правительства в Ново-Огарёво. Он также добавил, что одна из его дочерей испытала на себе первую российскую вакцину от коронавирусной инфекции, сообщает ТАСС.
Ранее Федеральная служба по надзору в сфере здравоохранения (Росздравнадзор) не поддержала предложение Ассоциации организаций по клиническим исследованиям, которая объединяет российские фармацевтические компании, отложить государственную регистрацию отечественной вакцины от COVID-19 до завершения третьей фазы её клинических испытаний.
Как сообщила РБК заместитель главы Росздравнадзора Валентина Косенко, этой вакциной привили несколько сотен добровольцев, у них не возникло серьезных нежелательных реакций на неё. "Вакцину нельзя зарегистрировать, пока не завершены исследования, – никто не будет нарушать законодательство", – добавила Косенко. Она отметила, что на третьей – пострегистрационной – фазе исследований вакцины в испытаниях будут участвовать несколько тысяч добровольцев, что допускается и в условиях пандемии. "Очевидно, что АОКИ, не зная никаких результатов, делает выводы", – считает заместитель главы Росздравнадзора.
Фармацевтические компании призывали Минздрав "не форсировать разработку" вакцины, поскольку в мире насчитывается 26 вакцин-кандидатов, причем шесть из них тестируют с участием тысяч и десятков тысяч человек: "Ускоренная регистрация уже не сделает Россию лидером в этой гонке, она лишь подвергнет ненужной опасности конечных потребителей вакцины, граждан РФ".
Как рассказал глава Минздрава России Михаил Мурашко, вакцина зарегистрирована в виде раствора для инъекций. Она будет производиться на двух площадках - центром имени Гамалеи и компанией "Биннофарм". Первыми её получат медицинские работники и учителя. Вакцинация медиков может начаться в конце августа или сентябре. Препарат поступит в оборот с 1 января 2021 года.
Как сообщает Bloomberg со ссылкой на источники, некоторые московские медики и чиновники правительства Москвы получили предложение привиться от коронавирусной инфекции вакциной, которая ещё не была зарегистрирована. Cреди тех, кто получил приглашение сделать экспериментальную прививку, был заместитель председателя Общественной палаты Москвы, главный редактор "Эха Москвы" Алексей Венедиктов. Он отказался от вакцинации.